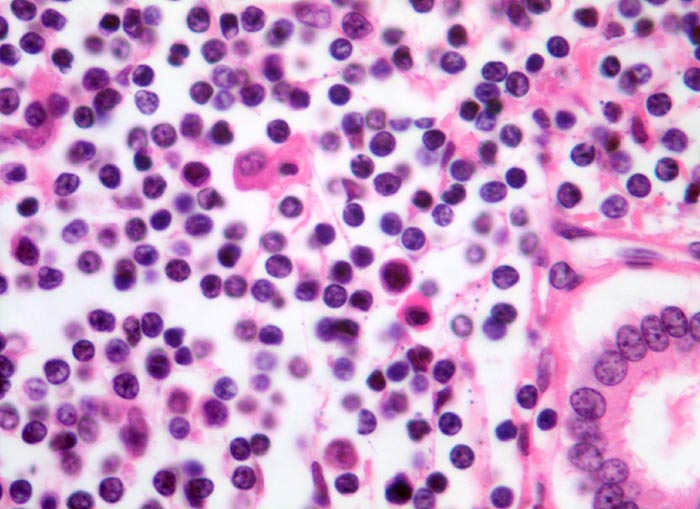

PathoPic – image database / PathoPic ID 3414 - Infiltration der Portalfelder: chronische lymphatische Leukämie (CLL)
de
Diagnose
Infiltration der Portalfelder: chronische lymphatische Leukämie (CLL)
Diagnose Gruppe
maligner Tumor
Topographie
Leber
Topographie Gruppe
Leber, Gallenwege, Pankreas
Beschreibung
Leukämisches Infiltrat von kleinen monomorphen lymphozytären Zellen. Im Unterschied zur Hepatitis finden sich praktisch nur Lymphozyten und keine Plasmazellen oder Histiozyten. Rechts unten im Bild ein Gallengangsanschnitt.
Zusatzbefund
-
Bilder Typ
Histologie
Vergrösserung
400
Alter
80
Geschlecht
unbekannt
Datum
Ersteintrag: 17.12.2001